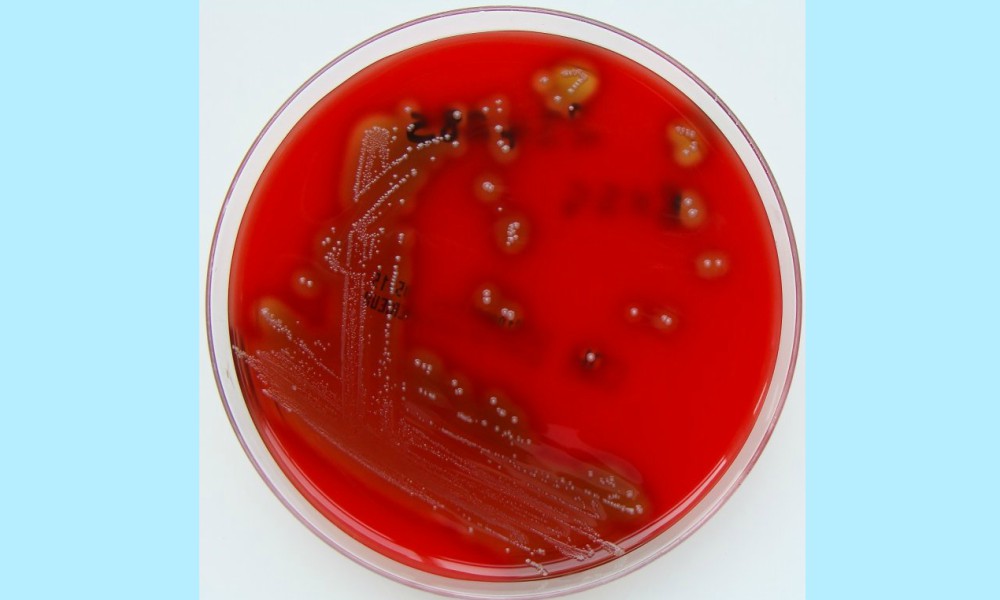

La muerte ocurrió el 3 de septiembre en un sanatorio privado de Roca (Río Negro), pero recién hoy trascendió que la causa del fallecimiento del bebé de 1 año y ocho meses fue un cuadro de infección generalizada por Streptococcus pyogenes.
El pequeño era oriundo de Viedma y fue derivado a Roca de urgencia ante la gravedad de su estado. “Ya tenía una patología previa, estaba con neumonía y se sobreinfectó”, precisó secretaria de relaciones Institucionales del Ministerio de Salud provincial, María de las Mercedes Iberó, según publicó el sitio web Río Negro. El caso no se había dado a conocer antes porque faltaba la confirmación del Ministerio de Salud de la provincia.







